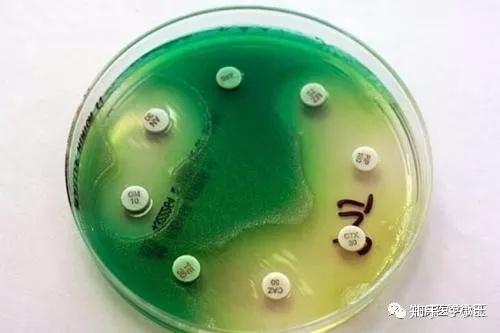
面对抗菌药物绿脓杆菌居然还能通风报信

绿脓杆菌培养基

默克merck绿脓杆菌培养基p基础1109880500
图片尺寸600x600
绿脓菌素测定培养基(pdp)用于绿脓杆菌的绿脓菌素测定试验.
图片尺寸500x441
(上图为在鸡舍水线中检测到的绿脓杆菌)这种情况一方面是由于我们给鸡
图片尺寸1071x1071
cetrimide agar是最常使用的选择性培养基,绿脓杆菌于此培养基上会
图片尺寸640x637
产品详情页-life technologies
图片尺寸650x600
默克密理博merck绿脓杆菌培养基预制1.46048.002020plates
图片尺寸600x400
铜绿假单胞菌绿脓杆菌
图片尺寸417x199
上海博微 乙酰胺琼脂培养基用于绿脓杆菌的选择性分离培养基250g
图片尺寸800x800
默克密理博milliporewl培养基1.10866.0500?
图片尺寸596x600
绿脓杆菌的分离培养及电镜照片(图片来源:中国科学院微生物研究所)
图片尺寸720x276
溴化十六烷基三甲铵琼脂培养基(中国药典) 250g
图片尺寸1000x1000
绿脓菌素测定用假单胞菌琼脂培养基pap
图片尺寸650x650
面对抗菌药物绿脓杆菌居然还能通风报信
图片尺寸500x333
【求助】绿脓杆菌的图片(照片)
图片尺寸2048x1536
绿脓菌素测定培养基(pdp琼脂培养基)
图片尺寸600x450
伤寒沙门氏菌粉红色菌落金黄色葡萄球菌抑制六,注意事项本培养基仅为
图片尺寸911x912
cmcc(b)10104 铜绿假单胞菌 cmcc(b)10211 铜绿假单胞菌 cmcc(b)26001
图片尺寸1280x960
维生素和生长因子;氯化钠维持均衡的渗透压;琼脂是培养基的凝固剂
图片尺寸2778x2778
绿脓杆菌
图片尺寸1298x1260
绿脓菌素测定用培养基用于绿脓杆菌的绿脓菌素测定试验.
图片尺寸374x355